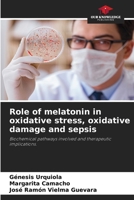
Role of melatonin in oxidative stress, oxidative damage and sepsis 6208687624 Book Cover

Agrarökologie in Venezuela: Erfahrungen mit analytischer Chemie und dem Lehr- und Lernprozess
Out of Stock

Agroecologia na Venezuela: Experiências em Química Analítica e o Processo de Ensino e Aprendizagem
Out of Stock

Agroecologia in Venezuela: Esperienze di chimica analitica e processo di insegnamento e apprendimento
Out of Stock

Agroecology in Venezuela: Experiences in Analytical Chemistry and in the Teaching and Learning Process
Out of Stock

L'agroécologie au Venezuela: Expériences en chimie analytique et processus d'enseignement et d'apprentissage
Out of Stock

Blastocystis spp. Infection: Update on Metabolism
Out of Stock

Enteroparasitas de interesse clínico.
Out of Stock

Enteroparásitos de interés clínico
Out of Stock

Entéroparasites d'intérêt clinique.
Out of Stock

Enteroparasiten von klinischem Interesse.
Out of Stock

Enteroparassiti di interesse clinico.
Out of Stock

Enteroparasites of clinical interest.
Out of Stock

Enteroparásitos de interés clínico (Spanish Edition)
Out of Stock

Biocombustibles en Venezuela (Spanish Edition)
Out of Stock

Biocarburants Au Venezuela (French Edition)
Out of Stock

Biocombustíveis Na Venezuela (Portuguese Edition)
Out of Stock

Biofuels in Venezuela
$48.21

Biocarburanti in Venezuela (Italian Edition)
Out of Stock

Biokraftstoffe in Venezuela (German Edition)
Out of Stock

Rol de la melatonina en el estrés oxidativo, daño oxidativo y sepsis (Spanish Edition)
Out of Stock
Role of melatonin in oxidative stress, oxidative damage and sepsis
$45.49

Rola melatoniny w stresie oksydacyjnym, uszkodzeniach oksydacyjnych i sepsie: Zaangazowane szlaki biochemiczne i implikacje terapeutyczne (Polish Edition)
Out of Stock

Ruolo della melatonina nello stress ossidativo, nel danno ossidativo e nella sepsi: Vie biochimiche coinvolte e implicazioni terapeutiche (Italian Edition)
Out of Stock

Papel da melatonina no stress oxidativo, danos oxidativos e sépsis: Vias bioquímicas envolvidas e implicações terapêuticas (Portuguese Edition)
Out of Stock

Die Rolle von Melatonin bei oxidativem Stress, oxidativen Schäden und Sepsis
Out of Stock